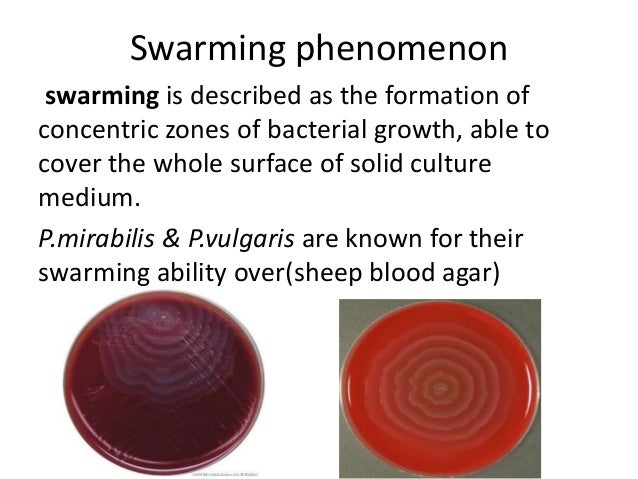
Proteus spp (2)

If you are looking for Proteus spp (2) you've came to the right page. We have 9 Pics about Proteus spp (2) like Chryseobacterium indologenes and actinomycete colonies on Mueller, Proteus spp lecture and also Some of the enterics are major pathogens of humans, but Proteus species. Read more:
Proteus Spp (2)
www.slideshare.net
www.slideshare.net proteus swarming phenomenon concentric
Some Nanoparticles Effects On Proteus Sp. And K Lebsiella Sp. Isolated
sp proteus figure
Details - Public Health Image Library(PHIL)
 phil.cdc.gov
phil.cdc.gov gram acinetobacter negative stain phil proteus vulgaris 1260 spp cdc bacterium photomicrograph numerous depicts bacteria stained library health quotes
Some Of The Enterics Are Major Pathogens Of Humans, But Proteus Species
proteus vulgaris mirabilis providencia matter organic microbiology plus species gram negative brcc cause particularly frequently genus tract infections urinary inhabitants
Proteus Spp Lecture
 www.slideshare.net
www.slideshare.net proteus emb lecture swarming
Modified Thayer-Martin Agar: Composition, Preparation, Uses And Colony
neisseria gonorrhoeae agar thayer martin colony characteristics modified preparation composition uses microbeonline source microbe
Gram Staining And Clinical Applications
 www.slideshare.net
www.slideshare.net cocci bacilli
Chryseobacterium Indologenes And Actinomycete Colonies On Mueller
 pinterest.com
pinterest.com colonies chryseobacterium hinton mueller actinomycete microbiology klebsiella
Proteus Spp (2)
proteus indole imvic mirabilis oxidase
Proteus swarming phenomenon concentric. Cocci bacilli. Some of the enterics are major pathogens of humans, but proteus species